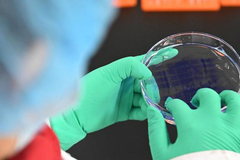

全天复盘
1月7日沪深两市涨停分析:胜通能源14连板,锋龙股份9连板
股市直击
2026-01-07 15:26:28
大盘直击
收评:沪指放量上涨0.05%收14连阳 半导体产业链全天强势
股市直击
2026-01-07 15:00:44
快讯:贵金属板块午后跳水 下跌个股近3200只
股市直击
2026-01-07 14:00:47
午评:沪指半日上涨0.29%逼近4100点 半导体产业链集体拉升
股市直击
2026-01-07 11:30:15
快讯:创业板指刷新阶段高点 北方华创等多股创历史新高
股市直击
2026-01-07 10:00:26
开盘:三大指数基本高开 存储芯片板块涨幅居前
股市直击
2026-01-07 09:25:11
盘中异动
快讯:三大指数午后集体翻绿 脑机接口板块跳水
股市直击
2026-01-07 13:27:54
盘前提示
财经早报:降准降息可期!央行2026年政策定调,A股新开户数创近三年新高丨2026年1月7日
新浪证券
2026-01-07 07:26:41
操盘必读:影响股市利好或利空消息_2026年1月7日_财经新闻
股市直击
2026-01-07 08:36:37
股海导航_2026年1月7日_沪深股市公告与交易提示
股市直击
2026-01-07 08:35:26
四大证券报头版头条内容精华摘要_2026年1月7日_财经新闻
股市直击
2026-01-07 08:33:07
市场资讯
用药利好!国家医保药品“清单”一览
澎湃新闻
2026-01-07 08:12:10
中信证券:预计2026年万得全A全年涨幅5%-10%
市场资讯
2026-01-07 08:11:01
股价涨超230%!13天11板嘉美包装今起停牌核查
澎湃新闻
2026-01-07 07:47:08
13连阳后A股怎么走?券商1月金股增配有色最多,紫金矿业最热
澎湃新闻
2026-01-07 07:46:13
买白酒能理财?汾酒一新品承诺两年后双倍回购引争议,多方回应
澎湃新闻
2026-01-07 07:56:12
中信建投:人形机器人产业加速落地 板块处于底部反弹阶段
市场资讯
2026-01-07 07:29:44
近3个月大涨超500%,大牛股突发停牌!新一轮找矿行动开启,有色金属牛市有望持续?
数据宝
2026-01-07 07:37:22
A股密集公告 提示相关风险!脑机接口突传重磅!
券商中国
2026-01-07 07:22:00
脑机接口商业化有望加速 大批概念股应声涨停
滚动播报
2026-01-07 05:02:55
2025年A股银行板块涨幅放缓 个股分化显著 机构看好2026年上市银行营收利润增速改善
滚动播报
2026-01-07 05:03:56
外盘头条
1月7日收盘:标普指数创新高,道指首次收在49000点之上
环球市场播报
2026-01-07 05:06:15
1月7日美股成交额前20:英伟达欲挑战特斯拉等公司的FSD主导地位
环球市场播报
2026-01-07 06:19:46
1月7日隔夜要闻:道指、标普均创历史新高 油价下跌 镍价飙升 金价走高 英伟达高管齐发积极信号
环球市场播报
2026-01-07 06:53:40
1月7日外盘头条:特朗普警告若输掉中期选举恐面临弹劾 xAI完成200亿美元融资 委内瑞拉债券成热门交易标的
环球市场播报
2026-01-07 05:59:55
1月7日热门中概股涨跌不一 拼多多涨2.97%,阿里巴巴跌3.43%
环球市场播报
2026-01-07 05:39:39
黄仁勋与现代汽车会长在CES会展间隙进行会谈
环球市场播报
2026-01-07 08:44:05
高盛2025年并购交易排行榜称王 百亿美元级巨案助推其市场份额
环球市场播报
2026-01-07 08:43:37
美国食品和药物管理局局长表示将限制对健康和健身可穿戴设备的监管
环球市场播报
2026-01-07 08:40:56